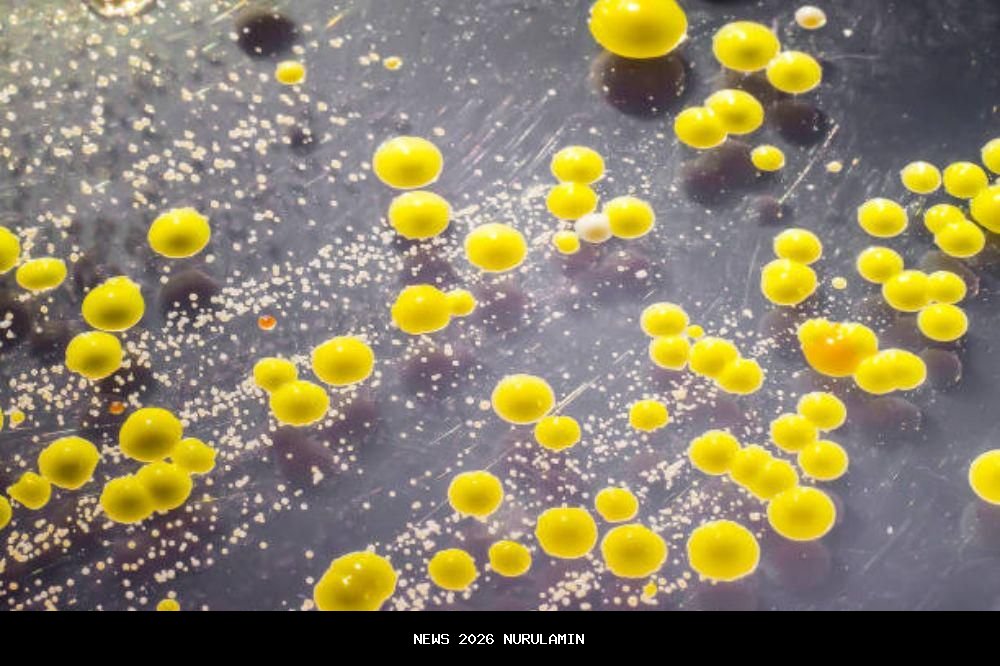

Penyebab Pembengkakan Kelenjar Getah Bening di Ketiak
Pernah merasa ada benjolan di ketiak atau kelenjar getah bening terasa membesar? Jangan panik dulu. Pembesaran kelenjar getah bening, atau limfadenopati, adalah respons alami tubuh terhadap infeksi, iritasi, atau kondisi medis tertentu. Meski sering bersifat jinak, pembesaran ini juga bisa menjadi tanda kondisi serius seperti penyakit autoimun atau kanker. Maka dari itu, jangan menyepelekan apabila terjadi pembengkakan kelenjar getah bening di ketiak.
Berikut adalah beberapa penyebab umum pembengkakan kelenjar getah bening di ketiak:
1. Infeksi bakteri atau virus
Infeksi adalah penyebab paling umum. Kelenjar getah bening bekerja sebagai “pos pemeriksaan” tubuh, menangkap bakteri dan virus. Saat Mama mengalami infeksi flu, radang tenggorokan, mononukleosis, atau TBC, sistem imun akan meningkatkan produksi sel imun, sehingga kelenjar membesar. Di Indonesia, infeksi kulit ringan akibat Staphylococcus aureus atau Streptococcus sangat umum memicu limfadenitis lokal di ketiak. Pembesaran biasanya disertai nyeri dan kemerahan, dan sering membaik dalam beberapa minggu jika infeksi diobati. Selama proses penyembuhan, kelenjar dapat terasa lembut dan bergerak, menandakan respons imun yang normal.
2. Efek vaksinasi

Vaksin bekerja dengan merangsang sistem imun untuk membentuk antibodi. Kadang, ini menyebabkan kelenjar getah bening membesar sementara, terutama di ketiak dekat tempat suntikan. Pembengkakan kelenjar getah bening bisa terjadi sebagai respons normal sistem imun terhadap vaksin. Kelenjar yang membesar akibat vaksin biasanya tidak nyeri dan tidak mengganggu aktivitas sehari-hari. Pembesaran ini dapat bertahan beberapa hari hingga beberapa minggu, tetapi tidak menimbulkan komplikasi serius.
3. Infeksi atau peradangan pada payudara

Pada ibu menyusui, mastitis adalah penyebab umum pembesaran kelenjar di ketiak. Infeksi atau penyumbatan saluran ASI membuat sistem imun bekerja ekstra, sehingga kelenjar di aksila membesar dan terasa nyeri. Pembesaran ini biasanya terjadi di sisi payudara yang terkena mastitis. Selain nyeri, bisa disertai demam ringan. Jika tidak segera ditangani, infeksi dapat menyebar ke jaringan sekitarnya dan memperburuk pembengkakan kelenjar. Oleh karena itu, penting untuk memastikan payudara dikosongkan secara rutin agar saluran ASI tidak tersumbat.
4. Penyakit autoimun

Penyakit autoimun terjadi ketika sistem imun menyerang jaringan tubuh sendiri. Kelenjar getah bening bisa menjadi salah satu target, sehingga mengalami pembesaran kronis. Mama yang memiliki penyakit autoimun mungkin merasakan benjolan di ketiak berulang kali, terkadang disertai nyeri atau kemerahan ringan. Perubahan ukuran kelenjar bisa muncul dan menghilang secara bertahap, mengikuti aktivitas penyakit autoimun. Pada beberapa kasus, pembesaran kelenjar bisa menjadi tanda flare-up atau kekambuhan penyakit.
5. Infeksi jamur atau parasit

Ketiak merupakan area lembab, sehingga jamur bisa tumbuh subur. Infeksi jamur atau parasit lokal memicu kelenjar getah bening bekerja ekstra untuk melawan patogen. Gejala tambahan bisa berupa rasa gatal, kemerahan, atau bau tidak sedap. Pembesaran kelenjar biasanya lebih ringan dibandingkan dengan infeksi bakteri, tetapi bisa menetap jika tidak diobati. Infeksi kronis jamur juga dapat memicu inflamasi berulang pada kelenjar getah bening. Disarankan untuk tetap menjaga kebersihan tubuh.
6. Reaksi obat

Beberapa obat tertentu bisa menimbulkan efek samping berupa limfadenopati. Obat antikejang seperti fenitoin, antibiotik tertentu, atau obat antiinflamasi kadang memicu pembesaran kelenjar. Reaksi ini biasanya akan membaik setelah penghentian obat yang menjadi pemicu, sesuai arahan dokter. Kelenjar biasanya terasa lembut dan tidak nyeri, tetapi tetap membesar selama beberapa minggu. Dokter mungkin akan memantau kondisi ini sebelum memutuskan untuk mengganti atau menghentikan obat.
7. Irritasi atau luka mikro di ketiak

Luka kecil akibat bercukur atau waxing bisa menjadi pintu masuk bakteri. Infeksi ringan ini memicu respons imun di kelenjar terdekat, sehingga terjadi pembesaran. Biasanya, pembesaran bersifat sementara, nyeri saat disentuh, dan akan mengecil ketika luka sembuh. Jika luka mikro terjadi berulang, kelenjar bisa tetap membesar lebih lama dan terasa lebih keras. Penting untuk menjaga kebersihan area ketiak agar proses penyembuhan berjalan optimal.
Diagnosis awal sangat penting agar penanganan bisa dilakukan lebih cepat. Pengawasan medis rutin membantu mencegah komplikasi lebih lanjut. Pembengkakan kelenjar getah bening di ketiak umumnya bersifat jinak dan disebabkan oleh infeksi ringan, vaksinasi, iritasi, atau reaksi obat. Namun, pembesaran yang menetap, keras, atau disertai gejala lain bisa menjadi tanda kondisi serius. Memahami pembengkakan kelenjar getah bening di ketiak, membantu Mama lebih waspada dan tanggap. Semua penyebab di atas perlu diamati, dan konsultasi medis diperlukan bila gejala mencurigakan muncul.










Diskusi Pembaca
Belum ada komentar
Jadilah yang pertama memberikan tanggapan!
Tambah Komentar